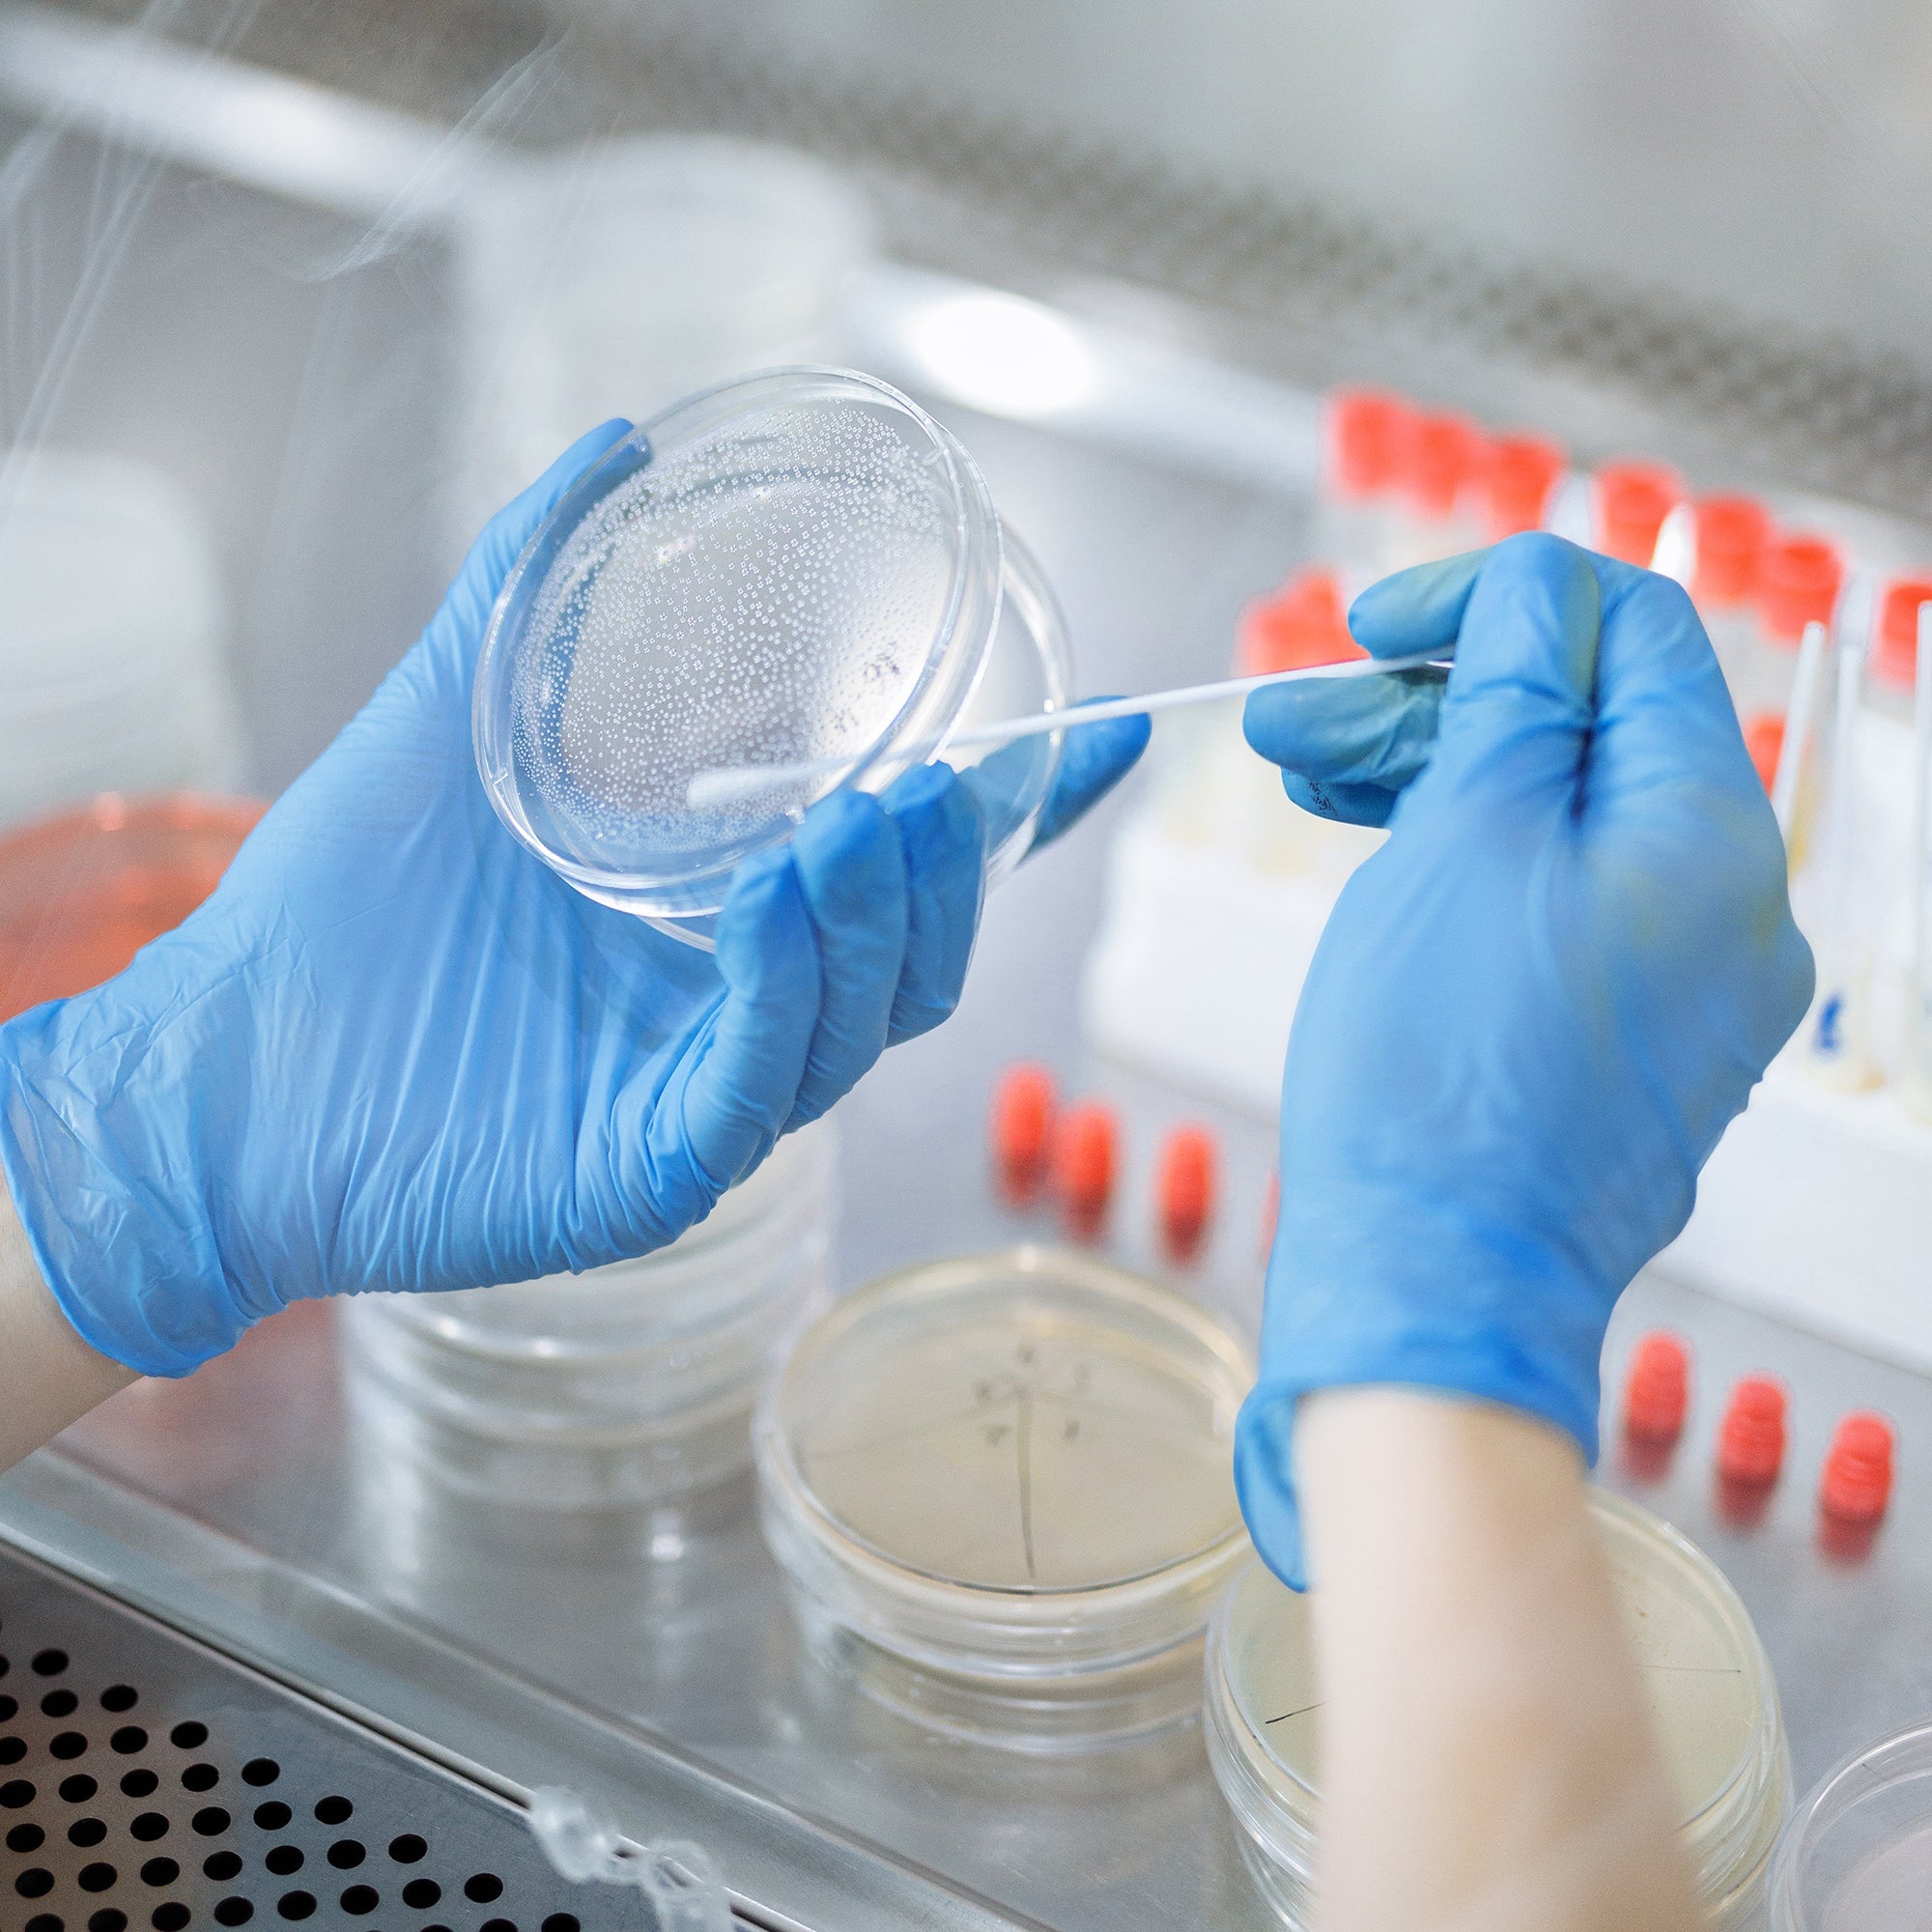
Schneider Disposable Vinyl Synthetic Exam Gloves 10x100 Case Pack - VSFB30 Blue - 4Mil - SchneiderDirect.com

Schneider Vinyl Gloves Latex-Free 4Mil Disposable Gloves Blue - (VSFB30)



Schneider Vinyl Gloves Latex-Free 4Mil Disposable Gloves Blue - (VSFB30)


Schneider Vinyl Synthetic Exam Gloves Blue (VSFB30)
Offers dependable protection for everyday medical, clinical, and general-use environments. Made from high-quality vinyl synthetic material, they provide a safe alternative for users with latex sensitivities. With their 4-mil thickness, these gloves balance protection, comfort, and affordability for consistent daily use.







These gloves deliver steady barrier performance against contamination, fluids, and common cleaning agents. Their 4-mil construction adds strength without feeling too stiff for routine tasks. This makes them a reliable option for light-to-medium exam work and basic caregiving needs.

The flexible vinyl blend allows the gloves to adapt naturally to your hand movements. Users can work longer with less strain thanks to their smooth, comfortable feel. Designed for extended wear, they remain easy on the hands even during repeat glove changes.

Each glove is designed for quicker donning, helping users switch pairs efficiently throughout the day. The material slides smoothly over the skin, making extraction simple and consistent. This feature supports fast-paced environments where time and convenience matter.

These gloves allow users to operate most touchscreen devices without removing them. This gives workers the ability to check digital charts, update records, or use mobile tools while staying protected. It helps maintain workflow efficiency in modern work settings.

The clean blue color creates a polished and hygienic look suitable for medical, dental, and caregiving spaces. It supports a neat, uniform appearance for teams that prioritize presentation and safety. Whether in clinics or home-care setups, the gloves help maintain a professional standard.






| Packaging |
50 Count, 100 Count, 1000 Count |
|---|---|
| Size |
Small, Medium, Large, X-Large |